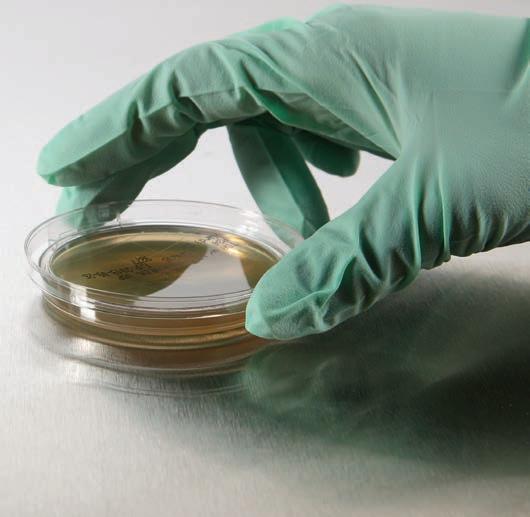

AND THE WINNER IS...
![]()









AND THE WINNER IS...

Top Seller
Smart Compounding - Low-linting, gamma-irradiated Sterile Chemo Prep Mats are compatible with ISO 5 cleanrooms.
Three Layers of Protection - Top is perforated film for even distribution; middle is air-laid paper for absorption; and bottom is impermeable polyethylene.
Packaging - 25 individually bagged mats per outer bag; 4 outer bags per case; 100 mats total

PERFORATED top layer, absorbent middle layer and non-permeable bottom layer

Easy to Use - Sterile, latex-free disposable syringes feature bold scale markings, tapered plunger rod for ease of aspiration, positive plunger rod stop and an added BD Luer-Lok thread for increased secure connection.
Sterile BD Luer-Lok Syringes, 1mL
Unique Size Option - Barrel outer diameter is equal to the BD 3mL syringe; inner diameter is the BD 1mL slip-tip syringe. 1/100mL graduations
Note - 19837 and 18906 - Rx only; federal law restricts the sale of these items to physicians or licensed medical practitioners.
Visit gohcl.com for lock options and mounting info.

Compact Design - Acrylic boxes are designed for compact units.
For longer bolts, please contact our Resource Group.


ü
ü
WARNING: Cancer www.P65Warnings.ca.gov
www.P65Warnings.ca.gov

Pull Tab enables quick access to medication.
Differentiate Product - Once the band is applied, the vial has a distinct look and feel different from traditional injectable medications.
Compatibility - Fits 10mL vials.
HCL®
D 16063
Compatible - Can be used with IV medications that require a low-protein binding filter.
Maximum Usage Duration – 24 hours
Maximum Operating Pressure – 30 psi
Total Hold-up Volume – 0.7mL
Flow Rate 0.9% (w/v) Saline at 1 m - 12mL/min
Construction:
20076 - Features a female luer lock inlet and male luer lock outlet.
Note - Rx only; federal law restricts the sale of these items to physicians or licensed medical practitioners.
ü E 20076
ü
WARNING: Cancer and Reproductive Harm www.P65Warnings.ca.gov




Special Features - Amber and Green blisters meet USP requirements for protection of UV light-sensitive medication. Blue blisters do not provide UV light protection.
Packaged - 24 blisters per sheet; 100 sheets per package; 2,400 blisters total


flap reads "void alert" when opened after sealing


Molds Easily - Flexible foil seals mold easily to containers and cannot be reapplied once removed.

Thickness - 2.75-mil
Special Features:
- Dual serial numbers and a tear-off receipt provide traceability. - Permanent pressure-sensitive adhesive
All in One - Comprehensive kit includes everything needed to ensure patient and employee safety when dealing with hazardous drug spills wherever they may occur. Each item inside the kit can be used to clean the HD spills, including kit packaging.
Greater Compliance - Contents have been specifically chosen to align with criteria defined by USP <800>, which outlines standards for hazardous drug handling. Safe-Sense™ Nitrile Exam Gloves are rated ASTM D6978-05.

HCL® Item # Qty.
ü A 19934 1
Includes:
- 20249 Anti-Skid Shoe Covers (2 pairs)
- 19346 Tyvek® Bouffant Cap (1)
- 19345 Anti-Fog Goggles, Non-Sterile (1)
- 18824 Chemotherapy Waste Bag, 12-16 Gallon (1)
- 18744 Chemo Sharps Container, 2-Quart (1)
- 19914 Green-Z® Liquid Solidifier (2 pouches)
- 19916 Bio Scoop and Scraper (1)
- 19918 Zorb Sheets 12" x 12" (5 sheets)
- 19845 Chemotherapy Disposal Slider Bag, 14 x 20 (1)
- 19900 Hazardous Drug Spill Warning Tent Sign (1)
- 20688L Safe-Sense™ Nitrile Exam Gloves, Large (2 pairs)
- 20688XL Safe-Sense™ Nitrile Exam Gloves, X-Large (2 pairs)
- 18331 Isolator Plus® N95 Particulate Respirator (1)
- 20429 Sterile HDClean® Wipes (3 kits)

- 19659L Protective Chemotherapy Apron with Sleeves, Large (1)



Built-in Storage - Cut and store tablets in the same pocket-sized container.



Safe Design - A cost-effective solution for fast, needle-free med transfer and reconstitution.
Trusted - Recommended by AORN as a needle-free alternative for dispensing medications to the sterile field.
Note - Rx only; federal law restricts the sale of these items to physicians or licensed medical practitioners.







Durable - Box is made of impact-resistant plastic that withstands daily use.
Smart Design - Built-in easy-grip handles Compatible - Box is compatible with Slide-In or Lift-Off Lids to secure and protect contents. Slide-In Lids available in Clear or Amber; Lift-Off Lids in Clear only.
Secure - Holes and lids allow security seals to be used for control and documentation.

www.P65Warnings.ca.gov WARNING: Cancer


This item is Single-patient use only.
Prevent Slipping - Pill Grip keeps the tablet in place; large cutting area holds up to 800mg tablets.
Tote Baskets Space


HAZARDOUS DRUGOBSERVESPECIALHANDLING, ADMINISTRATION AND REQUIREMENTSDISPOSAL

Improve Patient Safety - Tags rely on RFID technology to track items and allow users to quickly retrieve expired or recalled drugs. Visit StatStock.io to learn more.
Stay Organized - Holder keeps tags easily accessible in





Safer Access - Latex-free and non-DEHP for safe and simple access to IV bags.
Reduce Risk - Access port is self-sealing.
Bag Spike with SmartSite
Needle-Free Draws - Permits needle-free withdrawals from container without caps or clamps.



ü
Less Mess - Amber vials with graduations fill from the bottom and securely seal using plugs. Plugs are inserted with Plug Dispenser (7339) or HCL® LUD Press 2.0 (20932).
Tamper Evident - Factory applied foil seal provides a tamper-evident barrier.
Quick Filling - Vials are packaged on a plastic tray of 50 for quick bulk filling.
Size Options - Choose 15mL or 30mL
Quantity: 7733 and 7735 - 6 trays of 50; 300 vials with plugs total
Proper Use - The combination of Class B Blisters and Labels meets USP Class B package requirements.
Packaging - 20 blisters per strip; 125 strips per package; 2,500 blisters total



Material - Flame-retardant nylon can be wiped clean with surface disinfectant.
17677 - 3 pockets, 3 glove pockets and space for signage 17678 - 5 pockets, 3 glove pockets and space for signage 17679 - 3 pockets, 3 glove pockets, signage space and 2 large gown pockets on the back of the caddy that are accessible from the side.
Mounting Options - Includes metal hanger set.
Note - Meets California State Fire Marshal requirements for flame retardancy - Title 19.
ü B 17677* Personal Protection Door Caddy, 6 Pockets
33 ü 17678* Personal Protection Door Caddy, 9 Pockets
ü 17679* Personal Protection Door Caddy, 8 Pockets 181⁄2 x 33
*Specify color when ordering.


Built-in Storage - 2 compartments for medication storage




Compatible - Ideal for use with our Easy Shelving Systems, 12" deep shelving or hanging rails
Color Options - Blue, Clear, Gray, Ivory, Red and Yellow
*Specify color when ordering.
WARNING: Cancer and Reproductive Harm www.P65Warnings.ca.gov

Temperature Range - From 0° to 50°C and (32° to 122°F) with a resolution of 1° and maintains an accuracy of ±0.1°C/±0.1°F. Humidity range is from 25 to 95%, resolution is 1% RH, and accuracy is ±2% RH mid-range to ±4% RH elsewhere.
NIST Certified - Includes an individual serial-numbered traceable certificate.
Sensors - Fast-response solid-state sensors display changes in less than 30 seconds. Display is updated once per second.
Logging - Min/Max memory may be displayed or cleared at any time.
Display - Continuously and simultaneously displays relative humidity and temperature in °C or °F.
Power - Includes 2 AAA batteries.
Note - Annual recalibration is recommended.
Contents sold separately.

We offer a wide variety of labels! Contact our Customer Service TEAM.
Material - PVC
Convenient - Easy-to-use 7-day or 31-day packaging system
Preprinted - 7-day trifold cards are printed with the days of the week and 4 time slots (Morning, Noon, Evening and Bedtime). Cards for 31-day system are numerically printed.
Large Med Capacity - Increased blister capacity allows for the packaging of multiple medications in 1 blister.
Ready to Use - The cold seal system does not require special equipment for assembly. Plastic template aligns blister with sealing card. Foil backing is tamper evident.
Fast Transfers - Non-filtered for fast transfer of medication from rubber-stoppered vial to vacuumized IV container.
Smart Design - Features special anti-coring bevels.
Sterile Packaged - Individually sterile packaged in a protective sheath.
Sterile Double-Ended Transfer Needles, 17-Gauge 11⁄4" needle opposite x 3⁄4" needle
Note - Rx only; federal law restricts the sale of this item to physicians or licensed medical practitioners.
easily identify medications, instructions and warnings with increased surface area for labels.
What’s Included - Each pack includes 250 cards, 250 blisters and 1 plastic template sealing tray.
Cavity - 7-day blisters are 3⁄4" deep; 31-day blisters are 5⁄8" deep.

ü C 17841
Transfer Needles, 20-gauge
ü 17841-50 Sterile Double-Ended Transfer Needles, 20-gauge, case
ü D 17114 Sterile Double-Ended Transfer Needles, 17-gauge
ü 17114-31 Sterile Double-Ended Transfer Needles, 17-gauge, case
Memory-Loc locks in data and will not overwrite.

Excursion-Trac keeps the most recent 525,600 data points.

CDC Compliant - Yes
Temperature Range - From -50° to 70°C (-58° to 158°F) and resolution of 0.01 and maintains an accuracy of ±0.25°C/±0.25°F.
NIST Traceability - Includes an individual serial-numbered traceable certificate.
Logging - Logs 2 years of data in 1 minute to 24-hour intervals. When storage is full it stops recording and does not overwrite data.
Excursion-Trac -Maintains most recent 525,600 temperature observations.
Display - Shows current temperature as well as Min/Max temperatures. Choose Fahrenheit or Celsius display.
Programmable Alarm - Stores up to 10 unique alarm events in 0.1° increments. Records when the alarm occurred and when the unit returned within range. Alarm state indicators include visual LEDs, audio alerts and flashing LCD segments.
Data Retrieval - No software needed. Units can remain in use while downloading and analyzing data. Status indicators show low battery, memory full, USB data transfer and active alarm state. Recorded data (CSV file) can be transferred from thermometer to PC or Mac using a USB flash drive (not included). Each thermometer has a unique ID allowing multiple units to be used in the same location.
Power - Includes 2 AAA batteries.
Note - Annual recalibration is recommended.
CDC
ü 19196
ü A 19197
ü B 19198

CDC Compliant - Yes
Temperature Range - From -10° to 55°C (14° to 131°F).
Maintains an accuracy of ±0.5°C/±0.9°F. Measurement frequency is every minute.
ISO 17025 Certified - Includes ISO certification. Certification is required by CDC to confirm loggers are part of the Vaccine for Children program. Complies with FDA regulations 21 CRF Part 11.
Sensor - Removable external probe monitors temperature inside the refrigeration unit.
Alarm - Visual alarm indicates temperature violation. Units feature preset alarms to warn of temperature violation.
- Refrigerator preset alarms (19465): 60 minutes above 8°C (46°F) or 15 minutes below 2°C (36°F)
- Freezer preset alarm (19466): 60 minutes above -15°C (5°F)
Power - Includes 2 batteries that will last the life of the logger.
USP Compliant - Child-resistant cap conforms to USP “Tight” standards. Better Accuracy - Easy-to-read graduations



Powerful Crushing - Aluminum crusher provides very quiet, yet powerful crushing of tablets into a fine powder.

Tablets Stay Put - Tablets are crushed in durable, 6.25-mil pouches that hold tablets in place during crushing. Tablet Crusher Pouches will hold and crush approximately 5 tablets (depending on the size of the tablet).

Restrict Access - Indicates medication has been added and restricts port access.
Compatibility - Fits ExactaMed™ TPN Containers (PVC and EVA), Abbott® TPN Containers and Dual Chamber TPN Containers.
Quantity:
7979-03 - 25 caps per pack
7979-31 - 25 caps per pack; 25 packs per case; 625 caps total
7979-BULK - 1,000 caps per case
ü A 7979-03
ü 7979-31
Tamper-Resistant Add-Port Caps 25 for ExactaMed & Abbot
Tamper-Resistant Add-Port Caps 625 for ExactaMed & Abbott, case
ü 7979-BULK Tamper-Resistant Add-Port Caps 1,000 for ExactaMed & Abbott, case




Easy Patient Prep - Properly prepares a patient for surgery. Adhesive palm picks up loose hair and other foreign matter to provide a clean surgical field.

Better Patient Safety - Sterile seals protect the point of entry of IV admixtures from contamination and accidental double dosing.
Self Destructing - Upon attempted removal
Tamper-Evident - Needle punctures are highly visible in laminated foil.
Includes:
- (1) 1,000mL TSB Dual Port Bag (filled 700mL)
- (6) 100mL Sterile Dual Port Bags (empty)
- (6) 20mL Sterile Serum Vials (empty)
- 1 Whirl-Pak® Bag
- 1 Results Log Sheet


Better Results - Hydrophilic Supor membrane provides superior throughputs and flow rates.
Smart Design - Double luer-lock design for secure needle and syringe attachment.
Compatibility:
12548 and 12551 - Can be used for filtration of TPN additives and extemporaneous preparations.
12549, 12550 and 12554 - Can be used for solutions with high particulate loads.
Size Options - Choose 25mm filters for volumes up to 100mL and 32mm for volumes up to 150mL.
Filtration Area - 2.8cm2 for 25mm filters and 5.3cm2 for 32mm filters.
Packaging - Individually sterile packaged
Note - Rx only; federal law restricts the sale of these items to physicians or licensed medical practitioners.
www.P65Warnings.ca.gov

CONNECT YOUR ENTIRE FACILITY
With Stat Temp, there are no monthly subscriptions or ongoing maintenance costs.
Worry less when the Wi-Fi goes down. Stat Temp sensors are designed with built-in storage for continual offline temperature readings until connections are restored.
Temperature Monitoring
Stat Temp tracks the room temperature along with the temperature inside your cold storage unit. Simply plug in the room tracking sensor and you're set!
During instances of power loss, readers continue to monitor for at least 3 days while offline.
Temperature monitoring is a responsibility in various departments. Increase efficiency by setting custom views and see only what matters to each department. The entire facility can work together without the clutter of seeing every sensor on their dashboard.
Easily monitor humidity levels and receive alerts when the user-set limits are reached.
Configure real-time alert notifications with the ability to immediately log course of action for accountability.
Retrieving data logs and organizing reports is tedious and time consuming. Stat Temp offers built-in reporting with just a few clicks.
Stat Temp easily connects to Wi-Fi networks. Simply enter the Wi-Fi credentials and in seconds the wireless monitoring begins.
NIST Certified Ultra-Low Sensor
CDC Compliant - Yes
Temperature Range:
21022, 21024: -50º to 50ºC (-58º to 122ºF)
21026: -40º to 85ºC (-40º to 185ºF), Humidity 0% to 100%
21028: -100º to -50ºC (-148º to -58ºF)
Temperature Accuracy - +/-0.2ºC (21022, 21024, 21026); +/-0.5ºC (21028)
Relative Humidity Accuracy - (21026 Only) +/-5%
Sensors:
21022, 21024 - Sensors are housed inside unbreakable silicone cases that can be placed within the wires on most refrigerator and freezer shelves to minimize obstructions.
21026 - Plastic probe monitors air temperature and humidity levels. Allows users to stay ahead of forthcoming CDC guidelines requiring pharmacies to record humidity levels.
21028 - Metal probe monitors medications in ultra-low freezers.
Data Logging - Wi-Fi-enabled temperature monitor (included) offers unlimited readings with user-selected logging rate from every 5 minutes up to every 30 minutes.
Note - Monitors work with 2.4GHz Wi-Fi networks only.
Set-Up - Once connected to Wi-Fi, the unit can be added to the Stat Temp website, stat-temp.io. The sensor will automatically be added to the dashboard.
Mobile-Friendly Reports - Cloud-based storage allows instant access to reports from a computer, tablet, phone or other connected device for process, compliance or inspection.
No Fees - There is no subscription fee for Stat Temp.
No Limits - Users have unlimited cloud storage and can have multiple Stat Temp monitors linked to their portal.
Online Portals - Create portals on the Stat Temp website for locations; view all units being monitored or sort to show less (ex. location only).
Permissions - Set user-defined permissions based on shifts or roles.
Alerts - Configure real-time and user-defined alerts via text, email or phone call with forced acknowledgment of solutions. Example: Call Calvin, Fred and Cindy M-F, 8 a.m. – 5 p.m.; email Annie and text Tim M-F, 5 p.m. – 8 a.m.
Power Source - Uses a standard USB-C plug. No batteries to change out.
Loss of Power - 3-day battery backup
Min/Max Log - Provides min/max data for the last 24 hours.
NIST - Includes a 4-year NIST certificate.
Monitor Dimensions - 4"W x 21⁄2"H x 1"D
Stat Temp - Patent #11477546
Sensor - 21022 & 21024 Patent #12,152,833
CDC





Chemo Waste Container, 18-Gallon
Material - Opaque polypropylene
Closure - Hinged lid system. Hermetic seal prevents leaks. Lid cannot be removed once closed. Audible click indicates secure closure.
Special Features - Molded handles make the container easy to carry. Containers are stackable when lids are in place.


Maintain Integrity - Cap shows the syringe is intact. Protect Contents - Blister package protects the sterility of unopened caps.
Quantity:
8003-04 - 10 caps per tray
8003-31 - 10 caps per tray; 50 trays per case; 500 caps total
Note - Rx only; federal law restricts the sale of this item to physicians or licensed medical practitioners.


Operating Temperature Range:
19702 - Ambient +5°C to 60°C
20910 - 15°C below ambient to 60°C
Dual Functioning - Heats and cools (20910 only) to meet a wider range of regulations.
Easy to Use - Automatic operation and digital display. Features a large LED control panel that displays chamber temperature.
Small Footprint - Compact unit has a generous interior with 2 adjustable shelves. An internal outlet powers small instruments and minimizes cord clutter outside the unit.
Material - BloxTech™
Construction:
- Low-linting fabric is breathable
- Full closure back, hook and loop neck closure, knitted cuffs with thumb loops.
- Taped seams provide coverage against permeation.
Compatibility - Rated ASTM D6978-05
Sterilization - Non-sterile
Sizes - Small/Medium, Large/X-Large, 2X-Large/3X-Large and 4X-Large/5X-Large

Quantity - 10 gowns per bag; 3 bags per case; 30 gowns total






mL Only - Barrels are marked in milliliters only.

Active Ingredients - 70% IPA
Convenient Packaging - Non-woven presaturated cleanroom wipes are packaged in resealable pouches.
Lot numbered for traceability and a tamper-evident label on each package ensures product integrity.
Cleanroom Ready - Sterile presaturated wipes (18713, 18713-31) are gamma irradiated and are validated sterile to 10-6 per AAMI ISO 11137:2006 guidelines.
Quantity:
18713 - 30 wipes per pack
18713-31 - 30 wipes per pack; 48 packs per case; 1,440 wipes total
18712 - 30 wipes per pack
18712-31 - 30 wipes per pack; 50 packs per case; 1,500 wipes total
Monitor Bacterial Growth - Easily determine the efficiency of cleaning programs and aseptic techniques by monitoring the growth of bacterial colonies on incubated samples.
Ingredients - Tryptic Soy-based media is sterilized, then aseptically filled in an environmentally controlled room using automated equipment.
Expiration - Contact Plates have a 30-day expiration.
Dimensions:
19373 - 15mm deep x 60mm Dia.
19374 - 15mm deep x 100mm Dia.
Note - This temperature sensitive product will ship via UPS Next Day or FedEx Next Day. Product ships Monday-Thursday only. Refrigerate immediately upon arrival.
ü A 19373 Surface Testing Contact Plate, 60mm 10
ü B 19374 Fingertip Testing Contact Plate, 100mm 10

Covers entire prescription medication label

Tamper Evident - Protect sensitive patient information in compliance with HIPAA guidelines using this scored tamper-resistant label that self destructs upon removal.
Quantity:
7038 - 2 rolls of 500; 1,000 labels total 2300 - 1 roll of 1,000 labels total

Material - Made of industrial grade polymers
Improve Organization - Bins nest when not in use.
1435*
7184
16083
ü 9802-01
*Specify color when ordering.
9802-01:
WARNING: Cancer
www.P65Warnings.ca.gov



*Specify color when ordering.
9803-01 & 9702-01:
WARNING: Cancer
www.P65Warnings.ca.gov
*Specify color when ordering.
WARNING: Cancer
9803-01 & 9701-01: www.P65Warnings.ca.gov
*Specify color when ordering. 1942-01, 9803-01 & 9701-01: www.P65Warnings.ca.gov
WARNING: Cancer




Barrier Protection - Flexible foil seals offer a reliable moisture, particulate and bacterial barrier. Needle punctures are highly visible.
Sterile - Surface remains sterile until removed from the backing.

Vial Seals, 28mm
*Specify color when ordering.



Visible Evidence - Provides a tamper-evident solution for packaging medications.
Smart Design - Caps feature large ports for easy filling. Vials are graduated every 5mL with raised markings. Tab on the cap snaps into the filling port to permanently close vials. Tab can be easily pressed closed with the HCL® LUD Press 2.0 and Holder for Vials (20932) or manually closed with effort. Tear-away strip allows for removal of the cap with a quick pull. Once pulled, it shows evidence of use and cannot be reattached.
Assembly Options - Choose assembled or unassembled vials with caps in 15mL or 30mL.



Tamper Tuf Vials can be used with liquids AND solids.




Simplify Administration - Two-piece design easily and smoothly administers medication.
Smart Design - Unique plunger style (0.5mL and 1mL only) reduces residual content.
Protect Contents - Dispensers include Self-Righting Tip Caps. Additional Self-Righting Tip Caps (16050) or Tamper-Evident Tip Caps (17286) for Comar Oral Dispensers available.
mL Only - Barrels are marked in milliliters only.
Plunger Color Options - Blue, Green, Red, White and Yellow
*Specify

Material - Aluminum
Construction:
- Holds 4 individual boxes or 2 double boxes of gloves
- 2 boxes of face masks
- Dispensing slot for gowns
Mounting Options - Includes keyhole slots for wall mounting or can hang over a door using a hanger (18310 sold separately).
Easy to Use - Converts a standard medication bottle into a filling device for oral dispensers.
Let Us Help - To match the right adapter cap to a bottle, request a sizing template from our Customer Service Team.
USA HCL® Item # Size Qty.
ü ü A 8012-10 20mm/B 20
ü ü B 7886-10 24mm/D 20
ü ü 8019-10 24mm/M 20
ü ü C 7883-10 28mm/E 20
ü ü D 8013-10 28mm/F 20
ü ü E 19541 38mm/I 20
WARNING: Cancer and Reproductive Harm www.P65Warnings.ca.gov





Size Options - Please note the bottle adapter insert sizes listed correspond to the outer neck of bottle and not the inside opening.
Note - May not be compatible with oil-based products.

ü F 17282 20mm 20
ü 17283 24mm 20
ü G 17284 28mm 20
ü 17285 33mm 20
- 2-mil







Dual-purpose Cap - Creates a storage compartment or a shaker for crushed meds.
All in One - Add liquid to crushed tablet then attach cap and shake for easy syringe draws or to dispense directly from cup.

Reduce Risk - Non-sterile seals visually identify tampering of syringes or other medical or non-medical devices.
Security & Accuracy - Translucent Red seal (19980 only) secures syringes and keeps markings and graduations visible for greater accuracy and efficiency.
Maintain Integrity - Fold over tip cap or twist around syringe cap on all types of syringes and infusers to maintain integrity of contents. Seals are easy to manipulate over odd-shaped products.
Single Use - Seals cannot be reapplied after removal.
Refrigerator Safe - Seals maintain adhesion when refrigerated or frozen.
Lint-Free Liner - Seals are packaged in a plastic clamshell dispensing container that will not shed particulate.



Material - Aclar®
Smaller Footprint - Allows blisters to fit and dispense trouble free from medication cassettes used in automated med dispensers.
Packaged - 10 blisters per strip; 160 strips per package; 1,600 blisters total
Material - Choose from Aclar® or PVdC
Packaged - 10 blisters per strip; 160 strips per package; 1,600 blisters total
Proper Use - Use with Class A Blisters to meet USP Class A package requirements.
Neat Application - Foil labels are paper topped. No adhesive is applied over the medication cavity or lift open tabs.
Class A Laser Labels for Condensed & Micro Blisters
Packaged:
6123 - 40 labels per sheet; 100 sheets per box; 4,000 labels total
6027 - 35 labels per sheet; 100 sheets per box; 3,500 labels total





ü ü A 7019 HCL® Class A Amber Blisters, Condensed, Aclar
ü ü B 7079 HCL® Class A Amber Blisters, Condensed, PVdC 1 across; 10 down
ü ü C 6123* HCL® Class A or B Laser Labels for Condensed Blisters 11⁄2 x 13⁄16 4 across; 10 down
ü ü D 6027* HCL® Class A Laser Labels for Micro Blisters 13⁄16 x 13⁄16 5 across; 7 down 3,500


*Laser labels should be stored at 70˚ to 80˚F and 50% relative humidity (±5%) away from heat sources and direct sunlight. Labels should be stored in the room in which they will be printed at least 48 hours prior to printing. Not for use with thermal printers.
Average Breaking Strength - 8 lbs.
Material - Polypropylene
Dimensions - 11⁄2" x 17⁄8"
Tools Needed for Removal - No





Eco Friendly - Low-linting wipes are made from 100% natural fiber.
Reliable - Durable, soft and autoclavable
Quantity:
17883 - 100 wipes per pack
17884 - 300 wipes per pack
17885 - 150 wipes per pack

Material - PVdC
Efficient Design - This medium-cavity, 16-blister block allows an entire grid of labels (6126) to be applied simultaneously.
Proper Use - Blister/label combo meets the USP Class A package requirements.
Quantity - 16 blisters per strip; 100 strips per package; 1,600 blisters total.

Durable - Crusher bags hold multiple tablets in place during crushing and help avoid cross contamination.
- 6.25-mil

Improve Patient Safety - Prevent accidental misconnections by using items compatible with ISO standard 80369-3.
Easy to Use - Non-sterile adapters make it easy to draw medication from bottles or med cups.
Versatile - Adapters with male ENFit connection are available in 5 sizes to accommodate a variety of bottle neck sizes. Bottle caps can be used with adapters in place.
Note - Rx only; federal law restricts the sale of these items to physicians or licensed medical practitioners.
Thickness - 2.75-mil
Special Features:
- Dual serial numbers and a tear-off receipt provide traceability
- Permanent pressure-sensitive adhesive flap reads “VOID ALERT” if opened after sealed



Versatile - Tape molds easily to almost any item.
Wax Paper Liner - Allows for easy removal from roll. Liner is slit lengthwise.

ü
ü



Use with Class B Blisters to meet USP Class B
Foil labels are paper topped. No adhesive is applied over the medication cavity or lift open tabs.
40 labels per sheet; 100 sheets per box; 4,000 labels total
Qty.
4 across; 10 down 4,000
†Laser labels should be stored at 70˚ to 80˚F and 50% relative humidity (±5%) away from heat sources and direct sunlight. Labels should be stored in the room in which they will be printed at least 48 hours prior to printing. Not for use with thermal printers.

Keep medication from getting stuck in the zipper closure and provide easier access to crushed contents.
Reduce Waste - Pouches work with any ENFit syringe. By crushing and dissolving meds directly inside the pouch, users significantly reduce residual medication waste. Threaded attachment provides a more secure syringe grip. No med cups or straws are needed.
ENFit Pouches,
Threaded, case


Tamper Evident - Clear, flexible containers feature administration ports and include a tamper-evident medication site.
Safe, Sterile Construction - Made without PVC, DEHP or latex. Ideal for sterile compounding.





Better Patient Safety - Sterile seals protect the point of entry of IV admixtures from contamination and accidental double dosing.
Self Destructing - Upon attempted removal
Tamper-Evident - Needle punctures are highly visible in laminated foil.
*Specify color when ordering.

Improve Patient Safety - Tamper-evident caps help guard against misuse from the time the syringe leaves the pharmacy until it is dispensed.
Easy to Identify and Use - Purple color indicates ENFit syringe. The non-sterile tamper-evident cap cannot be reapplied once removed and tampering is immediately evident when the outer sleeve is detached or missing. Caps fit all mL syringes.
Note - Before dispensing, be sure to remove the plastic sleeve and cap.

DIY Convenience - Create your own media fill challenge for up to 5 technicians by choosing the components that most closely represent your most complex procedure as required by USP <797>.
Includes: - (5) 100mL TSB Media Bag
- (5) 3mL TSB Ampules (dyed red)
- (5) 20mL Serum Needle Port Septum Vials
Tamper-Evident



Barrier Protection - Protects against contamination and accidental double dosing. Identify if a previously opened vial has been tampered with.
Note - For use with vials only.
Single Use - Gamma sterilized and intended for single use. The target area remains sterile until removed from the liner
Tamper-Evident - Foil outer layer provides visible evidence of a needle puncture. Leaves a printed "OPENED" warning and cannot be reapplied.
Refrigerator Safe - Seals maintain adhesion when refrigerated or frozen.
Convenient Packaging - Packaged in a clamshell container with hanging tab for dispensing.
USA HCL® Item # Description
ü A 18297 Steri-Tamp Tamper-Evident Vial Seals, 13mm 1,000
ü B 18298 Steri-Tamp Tamper-Evident Vial Seals, 20mm 1,000
ü C 18299 Steri-Tamp Tamper-Evident Vial Seals, 28mm 1,000



Sterile Barrier - Maintains a sterile barrier if properly applied.
Refrigerator Safe - Seals maintain adhesion when refrigerated or frozen.
Compatible - Caps fit Baxter® Viaflex®, Viaflow®, Intravia, Aviva and All-In-One EVA; B. Braun Excel® and Pinnacle®; and ICU Medical Port Bags – long port flexible containers.
USP <797> Friendly - Seals feature a lint-free plastic liner and are packaged in a plastic clamshell dispensing container that will not shed particulate.


ü D 18296* 1,000
*Specify color when ordering. Removal leaves a printed “OPENED” warning and seal cannot be reapplied. D


Thickness - 1.5-mil
Closure - Adhesive closure
Write-on Block - White write-on area and tear-off receipt allows for easy documentation.



Reduce Diversion - Ready-to-use, all-purpose formula. Activated carbon slurry renders drugs nonretrievable, fulfilling current DEA guidelines. All-purpose formula accepts tablets, patches, ointments and liquids; just add medication and shake. Solution is reusable until the maximum tablet count is reached.
Safe Disposal - Once filled to capacity, bottles can be discarded with general waste. Customer should check with local DEA and EPA regulations to confirm guidelines for disposal within their municipality. Wall Mounts with Security Cable - (19723) Provide secure placement in a consistent location.
Don’t forget, you’ll need a separate cleaning tool for your HD prep hood.

Thorough Cleaning - Low-profile 360º swivel head ensures even cleaning in awkward spaces.
Easy to Clean - Autoclavable at 121*c for 30 minutes.
Easy to Use - Cleaning pads have a specially designed tab for quick, easy fitting to the 7" mophead frame with gloved hands.
Simplify Your Routine - Sterile EasyReach Presaturated Cleaning Pads are saturated with 70% IPA and 30% DI water. Presaturated pads reduce the number of materials introduced to the cleanroom and simplify the disinfection process.
Dimensions of Cleaning Tool Handle - 17"L 18276



Smart Compounding - Low-linting, gamma-irradiated Sterile Chemo Prep Mats are compatible with ISO 5 cleanrooms. Use during the compounding of hazardous drugs to contain spills and minimize unnecessary exposure.
Three Layers of Protection - Top is perforated film for even distribution; middle is air-laid paper for absorption; and bottom is impermeable polyethylene.
Packaging - 25 individually bagged mats per outer bag; 4 outer bags per case; 100 mats total


Economical - A disposable, cost-effective way to easily invert vials and bottles.
Safe Design - Plastic hanger secures bottle at 2 points for safe delivery.




Weight Limit - No more than 1 lb.
Additional Colors - Available through our Resource Group (Blue, Green, Red and Yellow).
HCL® Item # Description
ü ü C 18887 Bottle Hangers, 100mL Vials 25 ü ü 18887-31 Bottle Hangers, 100mL Vials, case 500
Deter Tampering and Diversion - Tampering is immediately evident when the outer sleeve is broken or missing.
Confident Drug Delivery - Help maintain the integrity of oral dispensers by restricting access to the tip with a solid tamper-evident closure that provides clear evidence of unauthorized access.
One Size - Caps fit all oral dispenser sizes.
Note for End Users - Before dispensing, be sure to remove the plastic sleeve and cap.
Note - Rx only; federal law restricts the sale of these items to physicians or licensed medical practitioners.
ü D 19856 Prep Lock Tamper-Evident Caps 100 for BD Oral Dispensers
ü 19856-31 Prep Lock Tamper-Evident Caps 1,000 for BD Oral Dispensers, case


Sterile - Solutions are packaged in small units with a twist-off cap that cannot be replaced to ensure a sterile dose every time, without all the waste of larger containers. Saljet saline is preservative and pyrogen free.
Easy to Use - Simply twist off the cap and squeeze. Users can adjust the stream by increasing pressure, up to 4-8 PSI. Drop by drop dispensing can be achieved by inverting the unit and applying gentle pressure.
Active Ingredient - Sodium Chloride 30ml (0.9% w/v)
National Drug Code - NDC 64938-009-01
Note - Rx only; federal law restricts the sale of this item to physicians or licensed medical practitioners.
Quantity:
13090 - 4 units per strip; 10 strips per box; 40 units total 13090-06 - 4 units per strip; 10 strips per box; 6 boxes per case; 240 units total

Category 2 CSP Media-Fill Test Kit
Includes: - (3) 50mL Vials containing test media - (6) 50mL Sterile Vials (empty) - (3) 10mL Sterile Vials (empty) - 1 Whirl-Pak® Bag - 1 Results Log Sheet





Average Breaking Strength - 11-14 lbs.
Material - Polypropylene
Total Length of Seal - 9"
Length of Seal Tail Only - 7"
Tools Needed for Removal - No





Patent #8,950,580
Deter Diversion - Durable IV lock box secures to an IV pole to keep controlled substances at the patient’s bedside.
Secure - Dual clamps snap onto the pole. When the door is closed and secured, the box cannot be removed without having access to the inside of the box.
Easy to Clean - Polycarbonate box can be disinfected with 70% isopropyl alcohol or PREempt™ (19954, 19955, 19956).
Lock Options - Models with key locks are keyed alike. Models with KEDL use a four-digit code and offer immediate access control. Contact our Resource Group for other keying and locking options.
#16
Top Seller

Compatibility - Accommodates IV bag sizes up to 1,000mL. For users of 1,000mL IV bags, ports will be outside the box. Locks to pole sizes up to 7⁄8" Dia.
NIST Traceability - Includes an individual serial-numbered traceable certificate.
Logging - Records Min/Max temperature from the last time the user manually clears the memory to the current temperature. Thermometer does not store readings.
Sensors - Glycol bottles
Display - Shows current temperature as well as Min/Max temperatures. Choose Fahrenheit or Celsius display.
Programmable Alarm - Programmable in 1° increments. Visual and audible signals continue even if temperature returns to non-alarm range for up to 12 hours.
Note - Annual calibration is recommended.
Temperature Range - From -50° to 70°C (-58° to 158°F); resolution 1°. Maintains an accuracy of ±0.1°C/±0.1°F.
Power - Includes 1 AA battery.
#15
Top Seller


Construction - 2 mil-thick sheets have adhesive coating with antimicrobial germicide that covers the full area of the mat.
Ready to Use - Mats remove dirt, dust and lint on contact from shoes.
Quantity - 30 sheets per mat; 4 mats per package; 120 sheets total

Top Seller #13




Top Seller
Material - Aclar®
Efficient Design - This medium-cavity, 16-blister block allows an entire grid of labels (6126) to be applied simultaneously.
Proper Use - Blister/label combo meets the USP Class A package requirements.
Quantity - 16 blisters per strip; 100 strips per package; 1,600 blisters total
For Beyond Use Date information go to: GoHCL.com
ü ü B 7016 HCL® Class A Amber Blisters, Small, Aclar 2 across; 8 down
ü ü C 7014 HCL® Class A Amber Blisters, Medium, Aclar 2 across; 8 down 1,600 ü ü 7015 HCL® Class A Amber Blisters, Large, Aclar 2 across; 8 down 1,600 ü ü 7004 HCL® Class A Amber Blister Block, Medium, Aclar® 4 across; 4 down 1,600

Sterility Assurance - Ideal for the preparation of sterile ophthalmic solutions.
All-in-One System - Includes snap-in dropper tips and screw-on caps. The 3mL dispenses approximately 42 μL with a tolerance of +/- 5 μL; 7mL, 10mL, 15mL and 30mL dispenses approximately 40 μL with a tolerance of +/- 5 μL.
7782 Sterile Dropper Bottles, 7mL
C 7790-01 Sterile Dropper Bottles, 10mL
ü 7790 Sterile Dropper Bottles, 10mL
ü D 7784-01 Sterile Dropper Bottle, 15mL
ü 7784 Sterile Dropper Bottles, 15mL
ü E 20658 Sterile Dropper Bottles, 15mL, Blue Caps
ü 20658-31 Sterile Dropper Bottles, 15mL, Blue Caps
ü F 7786-01 Sterile Dropper Bottle, 30mL
7786 Sterile Dropper Bottles, 30mL


High Quality - Ensure a clean finish and reduce the risk of residue.
Quantity:
18699 - 300 wipes per pack 17509 - 200 wipes per pack
17503 - 150 wipes per pack



#10 Top Seller
Improve Productivity - Ideal for volume capping of syringes during compounding. Sterile packaging tray provides immediate access to 10 sterile caps and allows users to open 2 caps at a time without compromising the remaining caps.
Compatibility - Caps fit all mL sizes.
Quantity: 19159-50 - 10 caps 19159 - 10 caps per tray; 10 sterile trays; 100 caps total
Note - Rx only; federal law restricts the sale of this item to physicians or licensed medical practitioners.
USA HCL® Item # Colors Qty. ü A 19159-50* 10 ü 19159* 100

Restrict Access - Indicates medication has been added and restricts port access.
Compatibility - Caps fit Baxter® Viaflex® Bags
Quantity: 4073 - 25 caps per pack
4073-31 - 300 caps per pack; 3 packs per case; 900 caps total
Bags 25 4073-31
Add-Port Caps for Baxter Viaflex Bags, case 900

ExactaMed™ Oral Dispensers with Tip Caps
mL Only - Barrels are marked in milliliters only.
Details - All dispensers feature silicone plunger O-ring seals.

All of These dispensers come with tip caps!

Patent #9,168,202 and #10,426,699
Easy to Use - Easily dock medication vials to Baxter® Mini-Bag Plus containers.
Compatibility - Designed for vials up to 50mL with 20mm caps.
Compatibility - Sterile, latex-free adapter is designed for use with single-dose vials with 20mm closure and VIAFLEX™ containers.
Sterile - Individual blister packs ensure sterility.

Quantity:
19120 - 50 per pack
19120-31 - 50 per pack; 4 packs per case; 200 devices total

Note - Rx only; federal law restricts the sale of this item to physicians or licensed medical practitioners.






Proper Use - Use with Class A Blisters to meet USP Class A package requirements.
Neat Application - Foil Labels are paper topped. No adhesive is applied over the medication cavity or lift open tabs.
Quantity - 32 labels per sheet; 100 sheets per box; 3,200 labels total
Dimensions
USA HCL Item # W x H
ü ü A 6121*† 111⁄16 x 13⁄16 4 across; 8
*Specify color when ordering.
†Laser labels should be stored at 70˚ to 80˚F and 50% relative humidity (±5%) away from heat sources and direct sunlight. Labels should be stored in the room in which they will be printed at least 48 hours prior to printing. Not for use with thermal printers.
Better Integrity - Helps maintain the integrity of a luer-lock syringe. Restricts access to the tip and leaves behind a plastic sleeve when the cap is removed to indicate use or tampering. Reduce Risk - Sterile packaging allows syringes to be capped directly from the tray, which reduces the risk of contamination.

Convenient - Sterile packaging tray holds 10 caps. Ideal for use under a hood for preparation of multiple syringes.
Compatible - Caps fit all luer lock syringes.
Note for End Users - Before dispensing, be sure to remove the plastic sleeve and cap.
Quantity:
17360-50 - 10 caps per tray; 1 sterile tray; 10 caps total 17360 - 10 caps per tray; 10 sterile trays; 100 caps total 17360-31 - 10 caps per tray; 100 sterile trays; 1,000 caps total
Note - Rx only; federal law restricts the sale of these items to physicians or licensed medical practitioners.




ü B 17360-50* Sterile Prep-Lock Tamper Evident Luer Lock Caps
ü 17360* Sterile Prep-Lock Tamper Evident Luer Lock Caps,case
ü 17360-31* Sterile Prep-Lock Tamper Evident Luer Lock Caps, case
*Specify color when ordering.

Thickness - 2-mil (1714 1.5-mil)
Convenient - Self-sealing adhesive closure. Perforated opening cannot be resealed once opened. Tears may indicate discrepancy in kit contents.
*Specify color when ordering.
Deep CC Box 1875-01, 3219


















3
Top Seller
Single patient use only

2 Top Seller

Two-in-One - Combines the convenience of cutting and crushing tablets in 1 tool.
Easy Cutting - Place a tablet in the triangular-shaped area and push down on the top cup.
Easy Crushing - Cups are designed for use in pairs with a grinding area located between the cup surfaces.
Durable - Cups are constructed of thick, heavy-duty plastic designed to withstand heavy grinding pressure.



UV Blocking - USP <671> states that observed spectral transmission should not exceed 10%. Green and Amber bags block 90% of UV light, Dark Amber bags block 98% of UV light. Transparent - Amber and Green covers are transparent.
ü 7586 Slit, Amber
ü
ü 7590L No Slit, Amber
ü 19640 Slit, Amber
ü 19643 Slit, Amber
ü 7579 Slit, Green
ü 7584 Slit, Green
ü 7583 Slit, Green
ü 19636 Slit, Green
ü 19642 Slit, Green
ü 7587D No Slit, Dark Amber
ü 7590 No Slit, Dark Amber
ü 7589D Slit, Dark Amber
ü 19641 Slit, Dark Amber
ü 19644 Slit, Dark Amber


Sterile Processed - Type 1, USP, borosilicate glass vials are dry-heat sterilized and pyrogen free.
Caps Included - 2mL vials have 13mm caps; all other sizes have 20mm caps.
ü A 20837 Sterile Empty Vials, Clear, 2mL 25
ü B 18492 Sterile Empty Vials, Clear, 5mL 25
ü C 18493 Sterile Empty Vials, Clear, 10mL 25
ü D 18494 Sterile Empty Vials, Clear, 30mL 10
ü E 18495 Sterile Empty Vials, Clear, 50mL 12
ü F 18496 Sterile Empty Vials, Clear, 100mL 12




